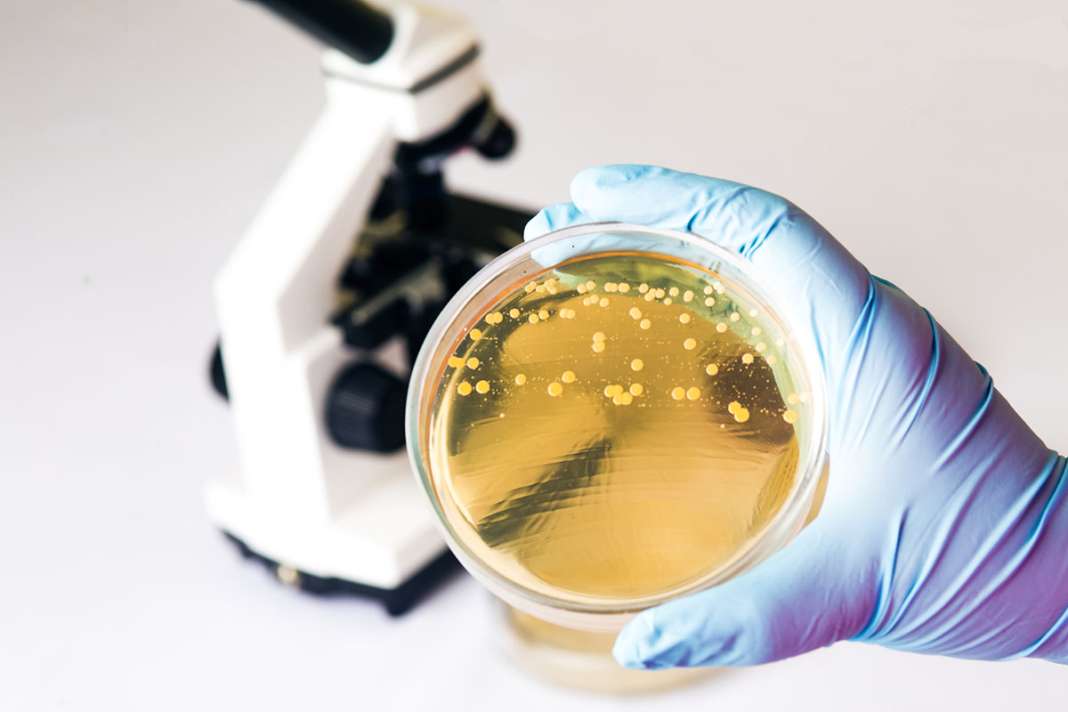

Candida auris je zelo nevarna glivica, predvsem za osebe z oslabljenim imunskim sistemom. Ameriški Center za nadzor in preprečevanje bolezni (CDC) je pred nedavnim objavil poročilo z zelo zaskrbljujočimi podatki. Strokovnjaki so namreč v letu 2022 zaznali občuten porast števila okužb v ZDA v primerjavi z letom 2021. Število primerov okužbe z glivico Candida auris se je namreč skoraj podvojilo, naglo povečevanje števila oseb, okuženih z omenjeno glivico, pa so zaznali tudi v nekaterih drugih državah …
Zabeleženih skoraj dvakrat več primerov kot leto prej
Leta 2021 je bilo v Združenih državah Amerike zabeleženih 756 primerov okužbe z glivico Candida auris. Glede na podatke, navedene v poročilu Centra za nadzor in preprečevanje bolezni, pa so leta 2022 v Združenih državah Amerike zabeležili skoraj dvakrat več primerov tovrstnih okužb, in sicer kar 1471.
Za nekatere skupine je okužba smrtno nevarna
Na srečo okužba z glivico Candida auris za osebe, ki so načeloma zdrave, ni pretirano nevarna. Toda kot omenjeno, lahko glivica resno ogrozi osebe, katerih imunski sistem je zaradi različnih razlogov oslabljen. Okužba z glivico Candida auris pa je lahko zelo nevarna tudi za bolnike, ki morajo uporabljati ventilatorje ali katetre. Pri teh osebah je hud potek bolezni zelo pogost, nemalokrat pa je ogroženo tudi življenje bolnikov, okuženih z glivico Candida auris.

Glivica postaja vse bolj odporna na razpoložljiva zdravila
Večina oseb, ki so bile testirane, je bila imuna na protiglivično zdravljenje. Zaradi glivične rezistence so strokovnjaki iz Centra za nadzor in preprečevanje bolezni dogajanje označili za zelo resno grožnjo, ki zahteva takojšnje ukrepanje. Ne narašča samo število primerov, ampak je mogoče sočasno opazovati naraščanje primerov okužb, pri katerih je bila zaznana odpornost na ehinokandine, skupino protiglivičnih učinkovin, ki se praviloma uporabljajo za zdravljenje okužbe.
Središče okužb so bolnišnice in domovi za starejše
Z glivico Candida auris se pogosto okužijo osebe v domovih za starejše in v bolnišnicah. Glivica se lahko širi prek stika z okuženo osebo ali prek stika s kontaminiranimi površinami in predmeti. Kot omenjeno, je lahko okužba celo usodna. Glede na dostopne podatke umre kar 1 od 3 oseb z invazivno obliko okužbe. Prvi primer okužbe v Združenih državah Amerike je bil sicer zabeležen leta 2016.
Naraščanje telesne temperature in mrzlica kot tipična simptoma
Eden od najpogostejših simptomov okužbe z glivico Candida auris je povišana telesna temperatura, ki jo lahko spremlja mrzlica. Omenjena simptoma pogosto vztrajata, tudi ko se začne zdravljenje. Ker je okužba z glivico najpogostejša pri osebah, ki so že v osnovi bolne, jo je pogosto težko diagnosticirati. Simptomi se lahko zamenjajo za simptome drugih bolezni. Za zanesljivo diagnozo je tako nujno laboratorijsko testiranje.
Neustrezni preventivni ukrepi kot posledica pandemije?
V poročilu Centra za nadzor in preprečevanje bolezni so kot glavni razlog za nagel porast okužb z glivico Candida auris navedeni neustrezni ukrepi za preprečevanje okužb v zdravstvenih ustanovah. To naj bi bilo vsaj deloma povezano s preobremenjenostjo zdravstvenega sistema med pandemijo.
Nevarnosti glivice se zaveda tudi Svetovna zdravstvena organizacija
Kot omenjeno, so porast primerov okužb z glivico Candida auris opazili tudi v drugih državah, ne samo v Združenih državah Amerike. Ena od držav, kjer so priča podobnemu trendu, je Kanada. Svetovna zdravstvena organizacija je sicer glivico Candida auris že lani uvrstila na seznam patogenih glivičnih organizmov, ki si zaradi resnosti grožnje za javno zdravje zaslužijo prioritetno obravnavo, kar zadeva raziskave, razvoj zdravil in ukrepe za zaščito javnega zdravja.
Preberite tudi: Kandida: Kakšni so simptomi in kako jo odpravimo